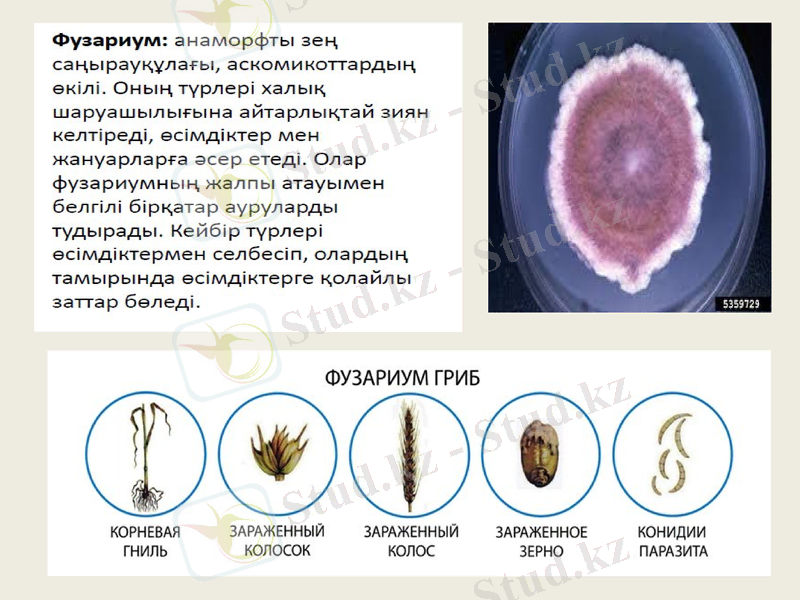
Slide 12

Эукариот микроорганизмдер: жасушалық құрылым және зең саңырауқұлақтардың Penicillium мен Aspergillus биологиясы мен маңызы



Эукариот микроорганизмдер
Орындаған: Медиум Сымбат
Айтқалиев Марат

Эукариоттар (грек. еu - жақсы, толығымен және karyon - ядро) - құрамында ядросы бар организмдер.
Эукариоттарға барлық жоғары сатыдағы жануарлар мен өсімдіктер, сондай-ақ бір немесе көп жасушалы балдырлар, саңырауқұлақтар және қарапайымдар жатады.
Эукариоттар жасушалары прокариоттармен салыстырғанда күрделі келеді. Эукариоттар жасушалары көптеген ішкі мембраналармен жеке бөліктерге (компартементтерге) бөлінеді. Бұл бөліктерде бір мезгілде бір-біріне тәуелсіз әр түрлі хим. реакциялар жүреді

Бұл жасушаларда ядро мен түрлі органеллалар (митохондрия, рибосома, Гольджи кешені) қызметтері жақсы жіктеледі. Клетка ядросы, митохондриялар, пластидтер цитоплазмадан екі қабат мембрана арқылы шектеледі. Ядрода жасушаның генетикалық материалдары (ДНҚ, онымен байланысқан заттар) шоғырланады.
Өсімдік жасушаларының хлоропластары негізінен Күн сәулесін сіңіріп, оны фотосинтез нәтижесінде органикалық заттардың химиялық энергиясына айналдырса, митохондриялар көмірсулар, майлар, ақуыздар, т. б. органикалық қосылыстарды ыдыратып энергия түзеді. Эукариоттар жасушалары цитоплазмасының мембраналық жүйесі (эндоплазмалық тор, Гольджи кешені) - жасуша әрекетін қамтамасыз ететін макромолекулаларды түзіп, жинақтайды. Эукариоттар жасушалары митоз жолымен бөлінеді

Эукариот микроорганизмдер қатарына:
Қарапайымдылар (амеба, жасыл эвглена, кәрпәкшелі кебісше т. б)
Микроскопиялық балдырлар
Микроскопиялық саңырауқұлақтар (ашытқылар және зең саңырауқұлағы)

Зең саңырауқұлақтары
Зең саңырауқұлақтары - аскомицет, гифомицет, фикомицет тобына бірігетін жетілмеген саңырауқұлақтар қатарына жататын төменгі сатыдағы өсімдіктер.

Бұларға тән ерекшелік өскен кезде үлпілдек, мамық тәрізді, түсі әр түрлі зең қабатын түзеді. Бұл қабат саңырауқұлақтың субстрат бетінде пайда болатын мицелийлерінен, спора түзгіш жіпшелерінен және спораларынан тұрады.
Зең саңырауқұлақтарының түсі түріне байланысты ақ, сұр, қара, көкшіл, жасыл, тағы басқа болып келеді. Өте ылғалды жерлерде және қолайлы температурада жақсы әрі тез өседі. Споралары, мицелий бөліктері, кейде жеке гифтері (жіңішке жіпше) арқылы көбейеді, тарайды.

Зең саңырауқұлақтары тағамда, өсімдік қалдықтарында, үйдің қабырғаларында (жабысып), көкөністе, тағы басқа жерлерде өсіп дамиды. Органикалық қалдықтарды ыдырату, шіріту және зат алмасу процесіне қатысады. Зең саңырауқұлақтары табиғатта кең тараған, кез келген тіршілік ортасында кездеседі. Олардың кейбір түрінен адамға қажетті заттар (витамин, антибиотик, органикалық қышқылдар) алынады.

Пеницилл, пенициллиум (Penicillium) - зең саңырауқұлақтарының үлкен бір тобы. Пенициллдің 250-ге жуық түрі бар, топырақ арасында көп таралған (1г топырақта 10 000 Пеницилл), органикалық қалдықтарды ыдыратады. Пенициллдер антибиоктер алуда, сыр дайындауда пайдаланылады. Мұнымен қатар жеміс, ет сүт т. б. тағамдарды, орылған астық дақылдарын, шөпті, мал жемін бұзып үлкен зиян да келтіреді. Пенициллдің көптеген түрі - адамның, малдың тері аурулары, тыныс алу органдары, ішкі органдары аурулары қоздырғышы

1928 жылы өзінің «салақтығынан», Флеминг пенициллин преператының негізін қалады. Ол Петри кеселерінің көгеріп кеткен біреуінің ішіне үңіліп, бактерия колонналарының мөлдір күйге енгенін байқайды. Соның арқасында ғылымға үлкен жаңалық әкеліп, бактериялық денелерді бұзатын пенициллин белсенді затын ойлап табады. Бастапқыда ол өзі ашқан жаңалықтың көмегімен дәрі жасауға болатынына аса сене қоймайды. Бірақ оның ісін Говард Флори мен Эрнст Борис Чейн деген мамандар 1940 - 1941 жылдар аралығында жалғастырып, пенициллинді тазалау әдісін тәжірибеге енгізді. Олар алғаш болып бактериялық инфекцияларға қарсы емдеу үшін қолданған.
Ал пенициллинді жаппай өндіру ісі Екінші дүниежүзілік соғыс кезінде жолға қойылды. 1945 жылы Александр Флеминг пен жоғарыда аттары аталған екі ғалымға физиология және медицина саласы бойынша Нобель сыйлығы табыс етілді.

Аспергилл -- аскомициттер класына жататын жоғары сатыдағы зең саңырауқұлақтардың жеке туысы. Олардың споралары конидиялардың ұшында орналасады; кейбір өкілдері құстар мен кеміргіштерде ауру туғызады

- Іс жүргізу
- Автоматтандыру, Техника
- Алғашқы әскери дайындық
- Астрономия
- Ауыл шаруашылығы
- Банк ісі
- Бизнесті бағалау
- Биология
- Бухгалтерлік іс
- Валеология
- Ветеринария
- География
- Геология, Геофизика, Геодезия
- Дін
- Ет, сүт, шарап өнімдері
- Жалпы тарих
- Жер кадастрі, Жылжымайтын мүлік
- Журналистика
- Информатика
- Кеден ісі
- Маркетинг
- Математика, Геометрия
- Медицина
- Мемлекеттік басқару
- Менеджмент
- Мұнай, Газ
- Мұрағат ісі
- Мәдениеттану
- ОБЖ (Основы безопасности жизнедеятельности)
- Педагогика
- Полиграфия
- Психология
- Салық
- Саясаттану
- Сақтандыру
- Сертификаттау, стандарттау
- Социология, Демография
- Спорт
- Статистика
- Тілтану, Филология
- Тарихи тұлғалар
- Тау-кен ісі
- Транспорт
- Туризм
- Физика
- Философия
- Халықаралық қатынастар
- Химия
- Экология, Қоршаған ортаны қорғау
- Экономика
- Экономикалық география
- Электротехника
- Қазақстан тарихы
- Қаржы
- Құрылыс
- Құқық, Криминалистика
- Әдебиет
- Өнер, музыка
- Өнеркәсіп, Өндіріс
Қазақ тілінде жазылған рефераттар, курстық жұмыстар, дипломдық жұмыстар бойынша біздің қор #1 болып табылады.



Ақпарат
Қосымша
Email: info@stud.kz